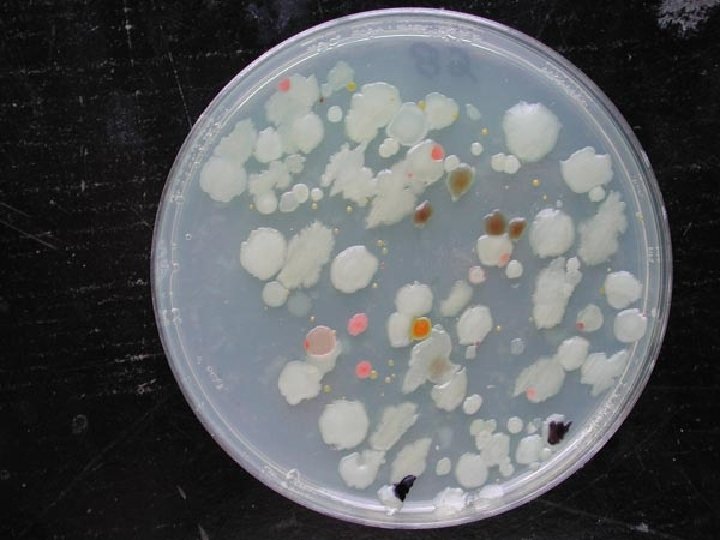
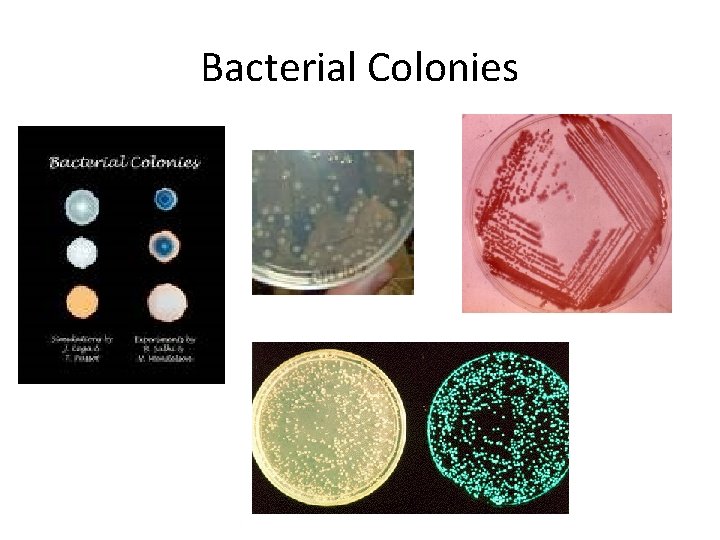
Bacterial Colonies
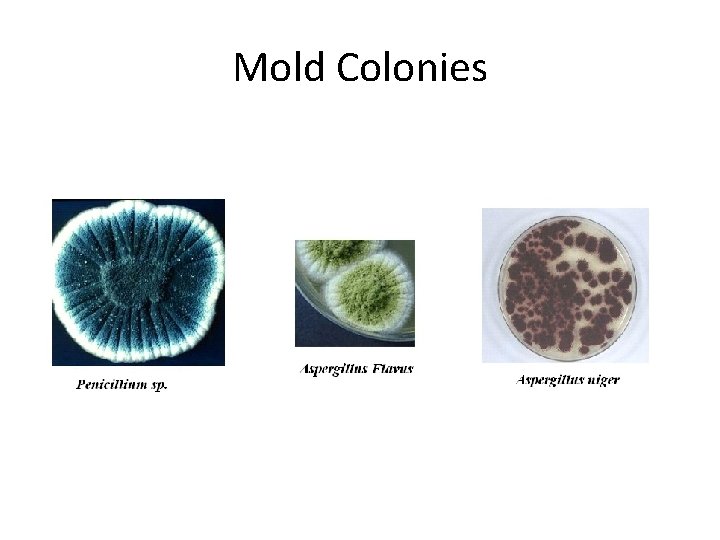
Mold Colonies
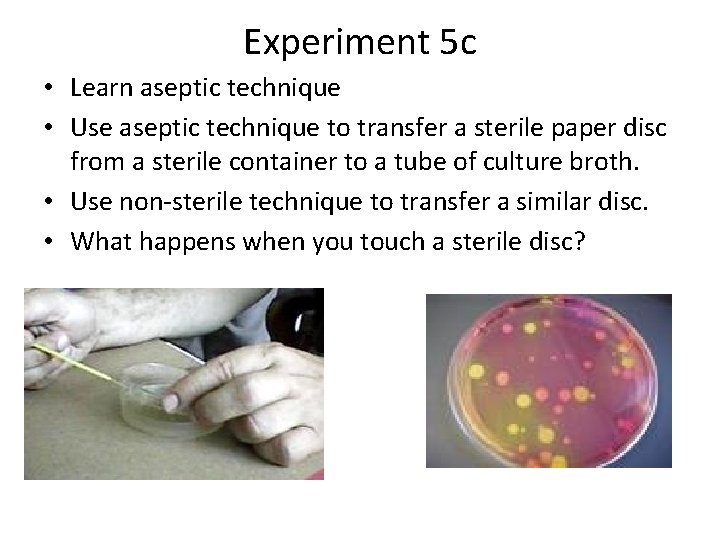
Experiment 5 c • Learn aseptic technique • Use aseptic technique to transfer a
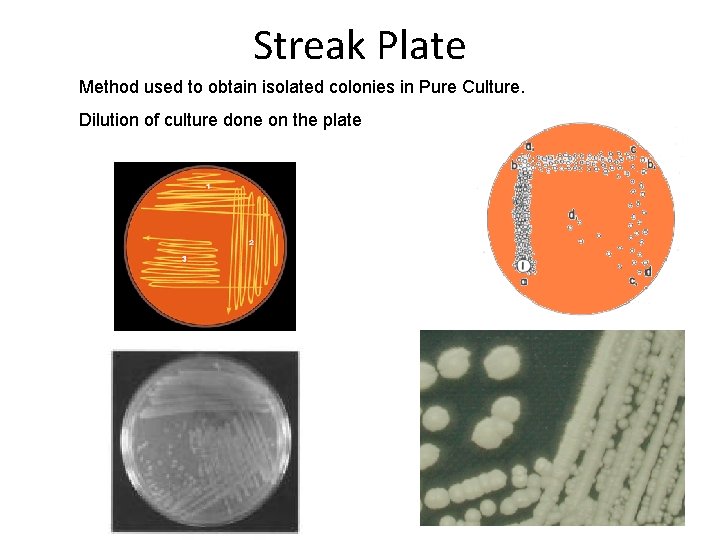
Streak Plate Method used to obtain isolated colonies in Pure Culture. Dilution of culture
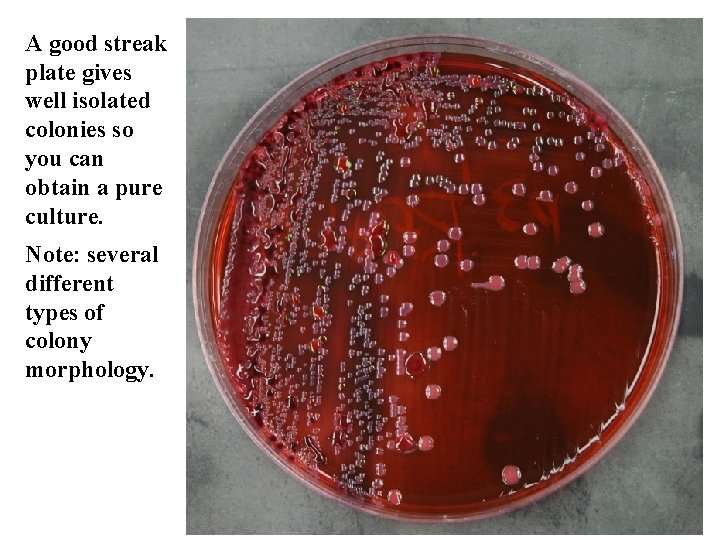
A good streak plate gives well isolated colonies so you can obtain a pure
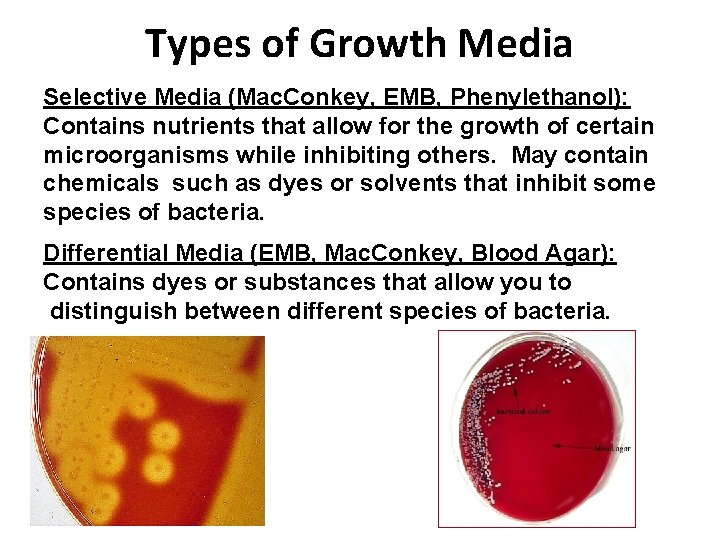
Types of Growth Media Selective Media (Mac. Conkey, EMB, Phenylethanol): Contains nutrients that allow

MCB 101 Introductory Microbiology Laboratory Lecture 3 September

MCB 101 Introductory Microbiology Laboratory Lecture 3 September 14, 2018 Today’s Topics -Experiment 5: Microorganisms in the Environment and Aseptic Technique - Experiment 6: Bacteriological Media and The Streak Plate

MCB 101 On-Line Homework Assignments LON-CAPA: Prelab – 3 Due at 8: 00 AM on Monday, Sept. 17 Covers: Aseptic Technique, Pure Culture, Media, and Streak Plates Experiments 5 & 6 pgs. 25 - 44 LON-CAPA: Quiz - 3 Opens today at 10: 00 AM Due: Friday, Sept. 21 at 8: 30 AM Covers: Aseptic Technique, Pure Culture, Media and Streak Plates pgs. 25 - 44 LON-CAPA: Pre-lab - 4 Opens today at 8: 00 AM Covers: Bacterial Nutrition, Enzymes & Adaptations Experiments 7 & 8 pgs. 45 – 67 Due: Monday, Sept. 24 at 8: 00 AM

Experiment - 5 Microorganisms in the Environment • Microorganisms are found just about everywhere. • To grow, microorganisms need water, proper temperature, proper atmosphere, an energy source – light or chemical, some microbes need organic nutrients • Survival is a different concept, some microbes can endure harsh conditions in a non-growing state, waiting for the environment to change and become favorable for growth and reproduction

Microorganisms in the Environment • Where do microorganisms grow? - In water: ocean, lakes, streams etc. - In soil: especially rich moist soil - Associated with plants - In the mouth, on the skin, in the gut • Where can microorganisms be found? - just about everywhere… all of the places listed above plus: floating in air and laying on barren surfaces

In some places you find a lot of bacteria while in other places you find very few. Environments that provide conditions that are conducive to microbial growth will generally be heavily colonized by bacteria, while harsh environments will have low microbial populations. Clean, dry surfaces such as quartz crystals and sand tend to have very low populations of microorganisms. This is not however the same thing as sterile.

Soil Microorganisms Associated With Plant Roots Right: Arbuscular Mycorrhizal Fungus seprl. ars. usda. gov Below: More Micorrhizal Fungi Below Right: Actinomycetes Associated With a Plant http: //www. blm. gov/nstc/soil/bacteria/

A Microbial Biofilm (Labeled view) lib. jiangnan. edu. cn The scanning electron micrograph shows the inside of a contact lens case, belonging to a patient with Acanthamoeba keratitis. Rod-shaped bacteria and Acanthamoeba cysts are visible in dehydrated form, a result of the electron microscopy processing. Amoebal cysts and trophozoites were cultured from the lens case. Scale bar = 1 micrometer. Louise Mc. Laughlin-Borlace Department of Pathology Institute of Ophthalmology London, England EC 1 V 9 EL United Kingdom

Color-enhanced scanning electron micrograph showing a wide variety of bacteria growing on the walls of a urine sample container. A microscope coverslip attached with double-sided sticky tape to the walls of a urine container became covered with a bacterial biofilm in two weeks. The container was used to collect the urine of a healthy person at night and was rinsed with water, not washed or sterilized, and then used again the next night. No bacteria were found by a medical laboratory in fresh urine collected from that person, so the bacteria shown are a contamination. Image width: 10. 7 micrometers. (from: publications. nigms. nih. gov)

Normal Microbial Flora of the Mouth • Different species colonize different areas. • • Biofilms • Mostly Gram positive streptococci • Alpha hemolytic • S. Veridans group (includes S. salivarius) • Surface of tongue has 100 bacteria/human cell • Saliva rinses teeth & buffers acids Fluorescence image of 15 different species of oral microorganisms. Image from: biotechniques. com

Normal Flora & Tooth Decay Streptococcus mutans microaerophilic, forms dextrin capsule, homolactic acid fermentation Lactobacillus acidophilus tolerates low p. H, makes more lactic acid, prefers anaerobic conditions Actinomycetes naeslundii Gram positive rods that are some of the first bacteria to colonize a tooth’s surface. Bacteriodes melanogenicus predominant anaerobic Gram negative bacillus isolates from mixed anaerobic infections of the upper respiratory tract Streptococcus mutans bacteria (pink) in dental plaque. image from: sciencephoto. com

ANUG Acute Necrotizing Ulcerative Gingivitis This extreme gum disease is caused by a mixed infection that include both aerobic and anaerobic bacteria.

Normal Flora of the Digestive Tract Stomach: none normally present - Helicobacter pylori involved in gastric ulcer formation Upper small intestine: 103 bacteria/ml Lower small intestine: 105 bacteria/ml - Aerobes & facultative anaerobes - Lactobacilli, streptobacilli, yeasts Colon: 1011 bacteria/ml - Mostly anaerobes

Types of Microorganisms (Single Celled Creatures) • Eukaryotes (have nuclei) - Fungi, mold and yeast - Algae - Protozoa • Prokaryotes (no nuclear membrane) - Bacteria - Archae (discovered by Carl Woese)

Bad Bacteria • Some Bacteria Cause Disease – – Strep throat (Streptococcus pyogenes) Botulism (Clostridium botulinum) Food poisoning (E. coli and Salmonella) Ulcers (Helicobacter pylori) • Some Bacteria Cause Cavities and Bad breath – Streptococcus mutans and Lactobacillus sp. – Anaerobic bacteria produce waste products from break down of sugars and protein • Some can contribute to metal corrosion (rust) • Some can be used in Biological warfare or Bioterrorism – Anthrax (Bacillus anthracis), the endospores survive harsh conditions and can be easily stored and dispersed – Bubonic plague (Yersinia pestis)

Good Bacteria • Some bacteria help plants and animals to digest and absorb nutrients • Some enrich the soil through Nitrogen fixation • Some degrade waste (sewage treatment) • Some are edible or used in food production Wine, cheese, yogurt, sauerkraut, bread, beer • Some bacteria produce antibiotics which can be used to help fight infections

Identifying Microbes – Colony Morphology • What do microorganisms look like? Microbes are too small to see, but if there is a pile of 100 million or more, you can see it. This is a colony. • Bacterial colonies can be described by: – Color – Shape – Size – Texture • In Experiment 5 you will learn how to describe and differentiate different types of bacteria based on colony morphology.

What is a Colony? • A colony is a pile of bacteria, yeast etc. growing on the surface of a substrate such as a plate of agar based medium. • Colonies consist of millions of cells, sometimes as many as a billion. • Colonies can arise from the growth and reproduction of a single cell

Bacterial Colonies
Mold Colonies


Experiment 5 a Microorganisms in the Air • Demonstrates presence of microbes in air • Shows how quickly uncovered surfaces can become contaminated • Gives different types of microbial colonies • Students should learn terminology describing colony morphology Sneezing spreads germs.

Experiment – 5 a Microorganisms in the Air Petri plates of a rich agar medium are left open for a while. After incubation, colonies are counted. The longer the medium is exposed, the more microbes (mostly mold spores) will land on the agar. Each pair of students will get 2 plates of rich medium. One plate will be exposed to air in the microbiology lab for 30 minutes. The other plate will be exposed to air outside for 30 minutes. Which plate will be more heavily contaminated?

Experiment – 5 b Microorganisms in the Environment • Part 1: Swab surface of spoon and inoculate a petri dish of a rich agar-medium. Theory: - Microbes on object will be transferred to the medium. - Tiny cells will grow into visible colonies. - The more microbes on the object, the more colonies will appear on the plate.

Experiment 5 b • Detection of bacteria on a surface • Culture from “clean” spoon • Culture from spoon that has been put in your mouth. • Which contains more bacteria?

Experiment – 5 c: Aseptic Technique • Aseptic means “without microorganisms” • Aseptic technique – Removes or kills microorganisms present – Prevents contamination of pure culture – Prevents spread of microorganisms • Technique is required to transfer cells from one vessel to another when working in lab • Everything must be sterilized before you begin • You will learn aseptic techniques for working with microorganisms

Exp. 5 c Aseptic Techniques • • Disinfecting work area Washing hands Flaming lips of test tubes Sterilizing equipment – Autoclaving – Flaming/Heating
Experiment 5 c • Learn aseptic technique • Use aseptic technique to transfer a sterile paper disc from a sterile container to a tube of culture broth. • Use non-sterile technique to transfer a similar disc. • What happens when you touch a sterile disc?

Right: To Sterilize Forceps (Tweezers) - Dip the tips of the forceps into ethanol - Ignite the ethanol and let it burn off - Let the instrument cool before using Sterile broth is clear. (left) Bacteria make the media turn cloudy or turbid. (right)

Procedure for Inoculating a Tube of Broth

Right: Sterilizing an inoculating loop in the Bunsen burner flame - Adjust gas flow and air to get a blue flame - Hold the loop in the flame at an angle - When the loop glows, it’s sterile, not too long -LET THE LOOP COOL BEFORE USING IT Bottom: When working with Petri dish cultures, minimize the time the is lid off. - Keep the lid between the agar and you. - Don’t lay the lid on the bench, hold it.

Experiment 6 - Pure Culture and the Streak Plate Method • What is a pure culture? - All of the cells in the sample are the same species - A clonal population, all of the cells in the sample arise from a single ancestor • Why are pure cultures important? – To successfully study – controlled experiments – Need to know for sure that the organism of interest is responsible for a test result – Need to know for sure which organism is causing an infection, so it can be properly treated

Pure Culture of Bacteria Definition: a pure culture starts from a single cell and contains only one type of organism All cells look the same under the microscope. All colonies on a plate of solid medium look the same. Goal: dilute the bacteria until you have a sample that contains a single cell then allow a population to grow from that isolated cell Techniques: Streak plate -- most common Spread plate (use fewer than 300 cells) Importance: To properly study the microorganism, its metabolism and ability to cause disease without interference from other microbes.

How do we get a pure culture? • Bacteria are too small to see, how can you manipulate them to get a single isolated cell so you can start a clonal population? Natural microbial biofilms contain a mix of bacterial species just like a natural forest contains a mix of trees.

How do we get a pure culture? • A good Streak Plate on a solid medium gives isolated colonies. • Dilution of a liquid sample then a Spread Plate on a solid medium – gives isolated colonies that can be counted to determine # of viable cells. • Dilute a liquid sample until the concentration of cells is about 0. 1 cfu/ml, inoculate several dozen tubes with 1 ml aliquots. Most tubes remain sterile, those that do show growth usually had one viable cell that is not seen in the spread plates. • Start a broth culture from an isolated colony • Start an agar slant culture from isolated colony or pure broth culture.
Streak Plate Method used to obtain isolated colonies in Pure Culture. Dilution of culture done on the plate

A good streak plate gives well isolated colonies so you can obtain a pure culture. Note: several different types of colony morphology.
Types of Growth Media Selective Media (Mac. Conkey, EMB, Phenylethanol): Contains nutrients that allow for the growth of certain microorganisms while inhibiting others. May contain chemicals such as dyes or solvents that inhibit some species of bacteria. Differential Media (EMB, Mac. Conkey, Blood Agar): Contains dyes or substances that allow you to distinguish between different species of bacteria.

Streak Plates - The Media 1. Luria Agar (L-agar, LB) contains yeast extract and peptone. It is a rich, general purpose, complex medium. Peptone is an enzymatic digest of a protein, usually casein. 2. Phenolethyl alcohol plate, (PEA) Is a selective medium that inhibits Gram – bacteria. The Escherichia coli is suppressed but the Staphylococcus grows. 3. EMB agar and Mac. Conkey agar contain dyes that suppress Gram + bacteria. They are selective media. 4. EMB agar and Mac. Conkey agar contain dyes that change colors when the p. H changes. Bacteria that ferment lactose make dark colonies on EMB (purple-green). Bacteria that ferment lactose make brick red colonies on Mac. Conkey agar. EMB and Mac. Conkey agars are both selective and differential.
- Slides: 40